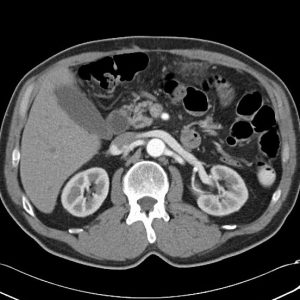
Nhồi máu mạc nối

TIÊU HOÁ
Hiển thị 701–720 của 1445 kết quảĐã sắp xếp theo mới nhất
-

Viêm ruột thừa
Lượt xem: 260» 16-05-2020 -

Viêm túi mật
Lượt xem: 265» 15-05-2020 -

Chấn thương lách
Lượt xem: 192» 15-05-2020 -

Nhồi máu mạc nối
Lượt xem: 290» 14-05-2020 -

Kén sán chó
Lượt xem: 258» 11-05-2020 -

Nhồi máu mạc nối
Lượt xem: 263» 11-05-2020 -

Thủng tạng rỗng
Lượt xem: 250» 07-05-2020 -

Thoát vị nội
Lượt xem: 333» 05-05-2020 -

Xoắn ruột
Lượt xem: 391» 02-05-2020 -

Thoát vị nội
Lượt xem: 301» 02-05-2020 -

Thủng túi thừa
Lượt xem: 204» 01-05-2020 -

Viêm túi thừa
Lượt xem: 141» 01-05-2020 -

Viêm túi thừa
Lượt xem: 130» 01-05-2020 -

Xoắn manh tràng
Lượt xem: 158» 01-05-2020 -

Thủng tạng rỗng
Lượt xem: 1049» 26-04-2020 -

Túi thừa tá tràng
Lượt xem: 1139» 26-04-2020 -

HCC
Lượt xem: 138» 16-04-2020 -

U đại tràng
Lượt xem: 173» 16-04-2020 -

VRT thủng
Lượt xem: 177» 14-04-2020 -

Thủng túi mật
Lượt xem: 197» 14-04-2020